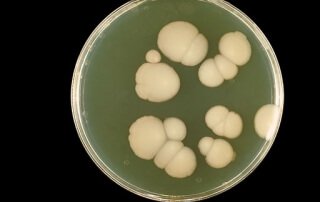
Dietary Control of Candida Overgrowth by Norm Robillard, Ph.D.

Dietary Supplements – Helping or Hurting Your Digestive Health?
Dietary supplements can be extremely helpful as part of a larger plan for addressing a variety of digestive and general health issues including: Vitamin and mineral deficiencies Microbiota imbalances Deficiencies in molecules made by the body such as stomach acid, bile and digestive enzymes Symptoms including gas, bloating, pain, diarrhea, constipation, [...]
How Pam is Getting Her Life Back from SIBO
Pam is one of Dr. Norm's clients for our consultation services. Her courage and persistence truly paid off to get her life back from SIBO. Congratulations, Pam! This is her story. I was 38 years old and healthy. I was running marathons, eating a near vegan diet and had never had any issues with my [...]
Diet over Drugs: 3 Step Plan for IBS, Diarrhea, Constipation, Bloating and Acid Reflux
Are you familiar with the term, Functional Gastrointestinal Disorders (FGIDs)? Don’t let this five-letter acronym intimidate you. It simply refers to conditions or symptoms affecting the digestive tract for which no structural problem or biochemical cause is observed by standard testing such as endoscopy, imaging or blood tests. These are some examples of FGIDs: Irritable [...]
Fast Tract Diet App for Gut Health
Hi guys, I am happy to let you know that the Fast Tract Diet App is now available on iTunes and Google Play. For those who are new to the Fast Tract Diet / Fast Tract Digestion books, you might not be aware that I also suffered severely for many years with chronic acid [...]
Can SIBO cause leaky gut?
Someone recently asked me if small intestinal bacterial overgrowth (SIBO) causes leaky gut, and if so, will the Fast Tract Diet help correct it?" SIBO is most definitely linked to leaky gut, and the connection goes a long way to explain why SIBO is linked to many autoimmune conditions including: Celiac disease Hashimoto’s Rheumatoid arthritis [...]
Why Do Many Doctors Over-Prescribe Drugs For Acid Reflux?
Acid reflux is one of the subjects that I am passionate about and my answer went beyond the usual scope of the Fast Tract Diet Q&A. Question about drugs for acid reflux "I am wondering why so many doctors are quick to prescribe drugs like proton pump inhibitors and H2 blockers, often both together for [...]
Dietary Control of Candida Overgrowth
Question on the Fast Tract Diet and Candida "I have successfully reduced SIBO to negligible, in part due to the Fast Tract diet. Thank you! The doctor indicates that candida is the chief problem now. Is the Fast Tract diet helpful for candida as well? I know candida is more yeast based and a different [...]
Fast Tract Diet Official Facebook Discussion Group
We recently launched the Fast Tract Diet Official Facebook Discussion Group. If this sounds interesting to you, please read the book, Fast Tract Digestion IBS or Fast Tract Digestion Heartburn, join the group and start posting! Our mission as a group is to help 10 million people (this also includes YOU) with functional gastrointestinal disorders (FGIDs) regain their health [...]
SIBO and Alcohol – Good News for Moderate Drinkers
What is the relationship between SIBO and alcohol? A recent study concluded that moderate alcohol consumption is a strong risk factor for small intestinal bacterial overgrowth, SIBO. Since then, I have been approached by several SIBO sufferers wondering if they should abstain from alcohol. This post addresses their concern and evaluates the study. But, before [...]
Is Rheumatoid Arthritis Caused by Alterations in Gut Bacteria?
I just read a great article called Joint Pain, from the Gut about the connection between two forms of arthritis and changes in our gut microbiota. I have posted on this in the past and the plot continues to thicken. The article highlights the recent finding that increased levels of a common gut microbe called [...]